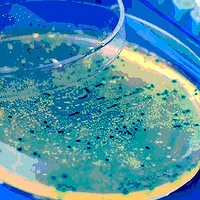
1113EMD.jpg

Accurate Detection of Microorganisms in Compressed Gases

Taking ISO standard 14698-1[1] into account, the test method using an MAS-100 CG EX® and the membrane-filter method were compared in a given pressure range. Both methods were applied under identical test conditions. Compressed air was used as the pressurized gas. Since ISO standard[1] Annex B (Guidance on validating air samplers) contains no instructions regarding the generation of aerosols in the pressure range concerned, this methodology had to be self-developed (the spinning-top or spinning-disc aerosol generator cannot be used in this pressure range). By using a self-developed ultrasonic nebulizing chamber, the spore suspension of Baccillus subtilis var. niger given in the ISO standard could be nebulized and then the microbial count was determined by membrane filtration or by the MAS-100 CG.
Description of MAS-100 CG Ex
The MAS-100 CG Ex is an air-sampling system that is based on the well-known impaction principle of the MAS-100.[2] The micro-organisms are directly impacted on a 90-mm standard Petri dish filled with culture medium. This air sampler was specially developed for the microbiological monitoring of pressurized gases that come into contact with finished product. The microorganisms are collected under working pressure, without risking a sublethal damage by the following decompression. The suction volume of 100 L/min is electronically controlled over a pressure range of 1.6 to 10 bar absolute pressure. Contrary to other systems, sampling is always performed in the defined pressure range. The instrument is delivered as an ex-proof version and thus is suitable for use in explosion-proof zones. By default, the MAS-100 CG is calibrated for air, nitrogen, argon and carbon dioxide, but it can also be calibrated for other gases.
Materials
• MAS-100 CG Ex with sieve plate, 300 × 0.6-mm holes, made of aluminum (CG)
• Membrane filter of mixed cellulose esters, 0.45-µm pore size, sterilized (MF)
• Air compressor Atlas-Copco, prefilter (type DD32) and afterfilter (type PD32), for separating oil, condensate and soil particles
• Ultrasonic nebulizing chamber, capacity approx. 500 mL, made of clear polycarbonate
• Vendor-prepared Tryptic soy agar
• Aqueous, concentrated suspension of Bacillus atrophaeus ATCC 9372 (former B. subtilis var. niger), Raven Biological Laboratories, Inc. Ethanol 80%
The bacterial suspension was prepared according to ISO standard 14698-1, Annex B; B 2.2.1 ff., so as to obtain a concentration of 1.0–1.5 × 104 CFU/mL in 80% ethanol. To obtain this concentration, the required volume of bacterial stock suspension was diluted with 80% ethanol.
Method
See Figures 1 and 2 for illustrations of the method.

Procedure
One hundred milliliters of the bacterial suspension (106 spores) were filled into the nebulizing chamber, and a (absolute) pressure of 2.6 bar was applied to the whole system. For a period of 30 seconds, a spore-containing aerosol was generated by means of ultrasonics. Subsequently this visible mist was either aspirated through a membrane filter, using a (dynamic) pressure of 1.6 bar, and placed on a Petri dish filled with TSA, or directly impacted onto a TSA Petri dish. (For technical reasons, the two test procedures could not be performed in parallel.) The agar plates were then incubated at 30 °C for 2 days.
With the filtration method, the aerosol was generated for 1 minute with an airflow rate of 10 L/min, which corresponds to the 20-fold volume of the nebulizing chamber. To attain an approximately equally long exposure period of the system, a test-gas volume of 250 L was selected, which, under a dynamic pressure of 1.6 bar, corresponds to a collection period of approximately 1.5 minutes.
With both procedures, a series of 10 individual samples was tested on each of three different days. The microbial recovery attained with the MAS-CG was expressed, according to the ISO standard, as a percentage of the membrane-filtration recovery. Additionally, the differences between the two procedures were checked statically using the Student’s t test.
Results
According to Tables 1 and 2, the barrier of significance for 2p 0.05 of the t test amounts to 2.10

Compared to the membrane-filter method, the MAS-100 CG EX has an average efficiency of 92%. According to the t test there is no significant difference between the microbial counts determined by the two procedures.
Discussion
Using ultrasonic nebulization, a spore-containing aerosol could be generated under pressure and the microbial count of this aerosol determined using the MAS-100 CG EX. Membrane filtration served as the method of reference. On three different days, a series of 10 individual samples was examined by each of the two methods and the results were statistically evaluated. All three test series yielded reproducible, corresponding results, which could be statistically proven by the t test. The average efficiency of the MAS-100 CG EX for approximately 1-µm particles is 92%. Since the cut-off value calculated[3] amounts to 1.12 µm, which means that practically all particles of larger diameter are separated by the MAS-100 CG EX. As regards the determination of the separated particles, the ISO standard specifics the use of five different concentrations of potassium iodide solution, which should yield particle sizes of 0.8–15 µm. As the separation rate for B. atrophaeus spores with a particle size of 1 µm attained with the MAS-100 CG EX was about the same as with the membrane-filter method, a detection of the larger particles is not necessary.
Based on the present, reproducible results, the MAS-100 CG EX enables the quantitative detection of microbe-carrying particles (approx. 1µm in size) under pressure conditions.
Summary
In a specially developed nebulizing chamber, a spore-containing aerosol was generated under pressure. The bacterial spore count of the aerosol was determined by the membrane filtration method and by means of an air sampler for pressure gases (MAS-100 CG EX). Based on three different test series, it could be proven that both test methods yielded statistically significant, reproducible results. By applying the impaction method, a collection efficiency of 92% could be achieved as compared to membrane filtration.
References
1. ISO 14698-1. Cleanrooms and associated controlled environments – Bio-contamination control – Part 1: General principles and methods (first edition 2003-09-01).
2. Meier, R. and H. Zingre. MAS-100. Qualification of air sampler systems: The MAS-100.
Swiss Pharma 1-2/00.
3. Nevalainen, A. et al. 1992. Performance of bio-aerosol samplers: Collection characteristics and sampler design considerations. Atmospheric Environment 26A(4): 531–540.
For more information, please visit www.millipore.com.
Looking for quick answers on food safety topics?
Try Ask FSM, our new smart AI search tool.
Ask FSM →